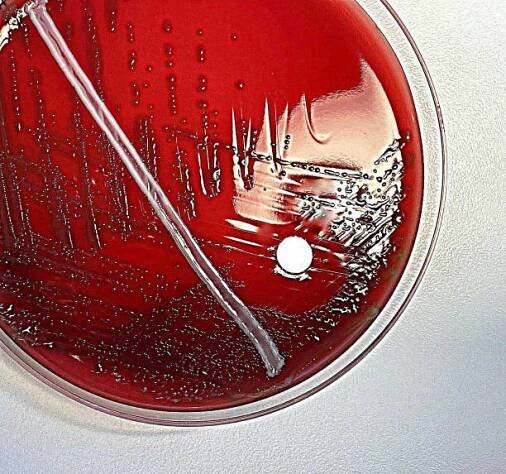

Streptococcus pneumoniae
Bakterie
Streptococcus pneumoniae, též pneumokok, je grampozitivní alfa-hemolytický, aerotolerantní anaerobní kok z rodu Streptococcus. Tato bakterie je významným lidským patogenem, byla identifikována jako hlavní příčina pneumonie konce 19. století a je předmětem mnoha studií humorální imunity. Navzdory svému názvu tento mikrob způsobuje, kromě pneumonie, řadu dalších… Wikipedia
Lidé také hledají
Streptococcus pneumoniae – Wikipedie
Streptococcus pneumoniae, též pneumokok, je grampozitivní alfa-hemolytický, aerotolerantní anaerobní kok z rodu Streptococcus. [1 ] Tato bakterie je významným lidským patogenem, byla identifikována jako hlavní příčina pneumonie konce 19.
Streptococcus pneumoniae - Wikipedia
Streptococcus pneumoniae, or pneumococcus, is a Gram-positive, spherical bacteria, alpha-hemolytic member of the genus Streptococcus. [1 ] S. pneumoniae cells are usually found in pairs (diplococci) and do not form spores and are non motile…
Pneumokok - Modrý koník
Pneumokok (Streptococcus pneumoniae) je patogenní grampozitivní fakultativně anaerobní bakterie. Tento druh streptokoků má lancetovitý tvar (tvar plamene svíčky či kopí) a vyskytuje se ve dvojicích.
Streptococcus pneumoniae | NZIP
Streptococcus pneumoniae neboli pneumokok je bakterie (přesněji řečeno jeden konkrétní druh streptokoka), která je zodpovědná za většinu případů komunitní pneumonie. Pneumokok ...
Streptococcus pneumoniae (protilátky) | laboratoře Synlab
Laboratorní test protilátek v profesionální zdravotnické laboratoři.
Cena 340 Kč
Nabídky ze Zboží.cz
Do týdne
od 99 Kč
3 375 Kč
Libristo.cz
Skladem
od 89 Kč
190 Kč
Empt.cz
odkazuje na služby nejen od Seznam.cz.
© 1996–2025 Seznam.cz, a.s.